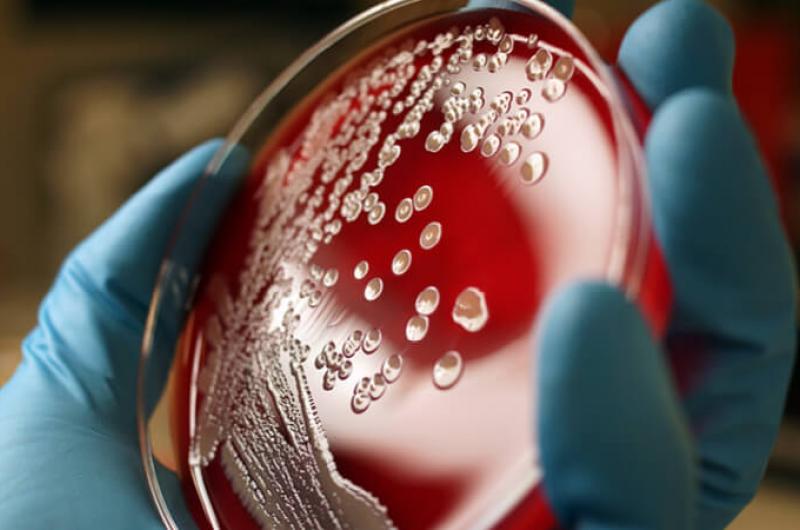

‘Vaccinatieonderzoek vraagt om moed’
Wanneer we denken aan mensen in beroepen waar veel moed voor nodig is, dan denken we snel aan soldaten, brandweerlieden en politieagenten. In de huidige coronatijd voegen we daaraan automatisch iedereen toe die in de zorg werkt. Logisch, want je moet dapper zijn om in deze tijd zorg te verlenen én onderzoek te doen naar een mogelijk vaccin. Dat is altijd al zo, maar corona maakt het moedige werk in de gezondheidszorg en medische wetenschap steeds zichtbaarder.

Iona Munjal is arts en gespecialiseerd in kinderinfectieziekten. Bij Pfizer ontwerpt en begeleidt ze klinisch onderzoek met vaccins. Zelf zegt ze over haar eigen werk: ’’Je moet dapper zijn in je onderzoek. Je zoekt de grenzen op. Dan kun je verwachten dat je vaker faalt dan slaagt. Je moet lef hebben om door te gaan. Dat is een belangrijk onderdeel in het kunnen doen van wetenschappelijk onderzoek.’’
Lessen leren
Volgens Munjal moet je moedig genoeg zijn om ondanks de vele tegenslagen door te blijven gaan. Zelf kreeg ze al de nodige lessen in het hebben én behouden van haar veerkracht. ’’Wetenschappelijk onderzoek vraagt om het hebben van een lange adem. Als het niet lukt zoals bedacht, moet je dat verlies accepteren en de moed hebben om verder te gaan.’’ Dat heeft Munjal zelf nog niet zo lang geleden ervaren bij het Staphylococcus aureus-vaccinprogramma en het bijbehorend klinisch onderzoek bij patiënten die een operatie ondergingen.
Staphylococcus aureus
De Staphylococcus aureus, ook wel stafylokok, is een bacterie die bij veel mensen voorkomt, vooral op de huid. In principe ‘woont’ deze bacterie daar zonder problemen, samen met miljoenen andere soortgenoten. De bacterie veroorzaakt normaal gesproken geen ziekte. Maar bij beschadiging van de huid of bij een operatie kunnen infecties ontstaan. Wanneer de bacterie dieper in het lichaam terechtkomt, kan deze verschillende ziektebeelden veroorzaken. Denk aan bloedvergiftiging, endocarditis (ontsteking aan de hartkleppen), abcessen, botontsteking, gewrichtsontsteking en longontsteking. Sommige Staphylococcus aureus-bacteriën kunnen giftige stoffen (toxinen) aanmaken en leiden tot onder meer het toxische shocksyndroom en voedselvergiftiging. MRSA (Methicillin-resistant Staphylococcus aureus) is een multiresistente bacterie. Dat betekent dat de bacterie ongevoelig is geworden voor behandeling met de meeste soorten antibiotica. De antibiotica werken dan niet meer tegen deze bacterie en daardoor is het moeilijker om de bacterie (en infectie) te bestrijden.
Ervaringen voor later
De Staphylococcus aureus-studie werd stopgezet omdat duidelijk werd dat de werkzaamheden niet zouden leiden tot een werkend vaccin. Natuurlijk was Munjal teleurgesteld. Toch wist ze dat gevoel om te zetten naar trots. Trots op de wetenschap achter het proefvaccin en trots op het ontwerp van de klinische proeven.
‘Wetenschappelijk onderzoek vraagt om het hebben van een lange adem’
’’We zijn er toch in geslaagd de proef met het vaccin veilig en effectief uit te voeren. Weliswaar niet met het gewenste resultaat, maar we hebben de nodige ervaringen opgedaan waarmee we later alsnog de wetenschap vooruithelpen. De lessen die we hebben geleerd, dragen bij aan het toekomstige vaccinwerk.’’
Immuunreactie
De ontwikkeling van een vaccin is een van de uitdagendste werkzaamheden bij het ontwikkelen van nieuwe geneesmiddelen. Bij andere medicijnontwikkeling kunnen wetenschappers onderzoeken of de gezondheid van een zieke verbetert. Bij een vaccin moeten de klinische onderzoeken worden geëvalueerd. Daaruit moet blijken of een kandidaat-vaccin een immuunreactie in het lichaam veroorzaakt.
’’Het lichaam is een compleet en krachtig hulpmiddel dat kan worden gebruikt om infecties te bestrijden’’, legt Munjal uit. Om aan te tonen dat een vaccin veilig en effectief is, moeten wetenschappers zeer nauwkeurig zijn in het opstellen van hun klinisch onderzoek.

Hernieuwde energie
Munjal werkt nu aan een immunisatieprogramma voor zwangere vrouwen tegen het Respiratoir Syncytieel Virus (RVS). RVS is het meest voorkomende verkoudheidsvirus bij kinderen. Bijna alle kinderen krijgen in het eerste levensjaar een infectie met dit virus. Het virus kan ernstige klachten veroorzaken bij jonge baby’s. Zij kunnen benauwd worden door een ontsteking van de kleine luchtwegen (bronchiolitis) of een longontsteking. Bij ouderen met een zwakke gezondheid is RVS een veelvoorkomende oorzaak van luchtweginfecties.
Zoals het een echte wetenschapper betaamt, heeft Munjal hernieuwde energie gevonden om een baanbrekend vaccin te vinden. Door aanstaande moeders te vaccineren kunnen zij hun pasgeborenen beschermen tegen een RVS-infectie. In Nederland komt sterfte door RVS bij kinderen nauwelijks voor, maar op andere plekken ter wereld overlijden er wel kinderen aan dit virus.
Van ziekenhuis naar wetenschap
Munjal werkte eerder zelf in het ziekenhuis. ’’Ik heb meerdere kinderen gezien die waren getroffen door RVS. Dat is het bijzondere van werken aan vaccins. Je kunt daarmee zoveel impact hebben op het leven van mensen.’’
De veerkracht en het doorzettingsvermogen van Munjal is er elke keer weer. Dat is niet zonder reden. Ze wil de impact van infectiezieken tegengaan bij moeders en hun kinderen én bij kwetsbare bevolkingsgroepen in lage en middeninkomenslanden. Met een van haar vroegste onderzoeken hield ze zich bezig met zwangere vrouwen met malaria. Later bestudeerde ze de hiv-overdracht van moeders op kinderen.

Na haar medische opleiding werkte ze als ziekenhuisepidemioloog en balanceerde ze tussen klinisch onderzoek en klinische zorg. ’’Ik was erbij om de reactie van het lokale ziekenhuis op opkomende infectieziekten als ebola, zika en andere mogelijke uitbraken te helpen organiseren’’, vertelt ze. ’’Het was een fantastische training.’’
Onderzoek naar vaccinonderzoek
Met haar passie voor het doen van onderzoek werkt ze nu bij Pfizer aan de strategie en het ontwerp van klinische vaccinonderzoeken. ’’Om een klinisch onderzoek uit te kunnen voeren, moet je creatief kunnen denken’’, aldus Munjal. ’’Dat is een van het leukste en interessantste aspecten van mijn werk. Tijdens het planningsproces proberen we aan elk onderdeel van de studie te denken. We denken bijvoorbeeld al na over hoe we artsen gaan benaderen, hoe we potentiële deelnemers bereiken en hoe en wanneer we gegevens kunnen vastleggen op een goede manier.”
‘Om een klinische proef uit te kunnen voeren, moet je creatief kunnen denken’
De onderzoeken die worden gepland voor de studie van RVS-vaccins, behoren tot de eerste studies naar een vaccin dat speciaal is ontworpen voor zwangere vrouwen en hun baby’s. Een van de dingen die Munjal heeft geleerd bij haar klinische studie naar Staphylococcus aureus, is dat ze nu weet dat je artsen kunt inschakelen die normaliter geen vaccins toedienen. ’’Ik werkte toen samen met chirurgen en orthopedisten. Die samenwerking heeft mij laten zien dat er meer mogelijk is dan je in eerste instantie denkt.’’
Het RVS-vaccinprogramma is voor haar dan ook het steeds verder verkennen van onbekend terrein. ’’En wat ik zo geweldig vind, is dat wij als wetenschappers niet bang zijn om daarmee aan de slag te gaan!’’
